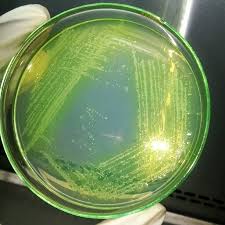

Agar Cetrimida

Agar Cetrimida Prolab

Cetrimide Agar S2 Media

Agar Cetrimida Wikipedia

Cetrimide Agar 100g

Pseudomonas Broth Broth Media Sigma Aldrich

Answered Citrate Test Cetrimide Agar Bartleby
Cetrimide is an antiseptic agent, meaning it has various antibacterial, antifungal and other antimicrobial properties and can be applied to skin or mucous membranes to avoid or minimize the risk of infection It is also a surfactant, meaning it functions as a detergent with cleaning properties As a pharmaceutical ingredient, it is used in various products like sprays, liquids, and creams for.

Agar cetrimida. VRBL (Violet Red Bile Lactose)/Agar 0 ml x 6 bottles $ List Price $4000. Cetrimida Agar es un medio selectivo y diferencial utilizado para el aislamiento e identificación de Pseudomonas aeruginosa partir de muestras clínicas y no clínicas Cetrimida es el agente selectivo e inhibe la mayoría de las bacterias al actuar como un detergente (bromuro de cetiltrimetilamonio, un amonio cuaternario, detergente catiónico). Cetrimide agar สามารถใช้ปลูกพืชตัวอย่างทุกชนิดที่มีอยู่ Pseudomonas aeruginosa ดังนั้นจึงมีประโยชน์ในทุกด้านของจุลชีววิทยา (สิ่งแวดล้อม, อุตสาหกรรม, คลินิก, น้ำและอาหาร).
El Agar Cetrimida es un medio selectivo para el aislamiento y recuento de Pseudomonas aeruginosa en productos biológicos, farmacéuticos y cosméticosLa composición se basa en la Farmacopea de los Estados Unidos. Cetrimide agar MSDS (material safety data sheet) or SDS, CoA and CoQ, dossiers, brochures and other available documents. Cetrimide or Cetrimide Agar is a selective solid culture medium designed for the isolation of Pseudomonas aeruginosa It is based on showing the production of characteristic pigments of this species and was made from the modification of Tech agar, created by King, Ward and Raney.
31 Agar Cetrimida Agar King Uso Medio de cultivo selectivo para el aislamiento de Pseudomonas aeruginosa a partir de diversas muestras Principio La cetrimida (Bromuro de cetiltrimetilamonio) inhibe el crecimiento de las bacterias debido a su acción como un compuesto cuaternario de amonio. Izvorna formula sadrži soli magnezijevog klorida, kalij sulfat, digestiju želatine pankreasa i agaragar Modifikacija formule sastojala se od dodavanja cetrimida (cetil trimetil amonij bromida) i glicerola Cetrimidni agar je koristan za mikrobiološka ispitivanja uzoraka na kojima je prisutna Pseudomonas aeruginosa. About Cetrimide Cetrimide has antiseptic properties and is used for cleaning wounds and treating minor burns, abrasions and scalds, and for curing seborrhoeic dermatitis This medication is also used for sterilizing surgical instruments This medicine contains properties including antibacterial, antifungal and other antimicrobial actions.
Cetrimida Agar Base USO Medio utilizado para el aislamiento selectivo de Pseudomonas aeruginosa y de otras especies del género Su fórmula cumple con los requerimientos de la Armonización de Farmacopeas Europea, Japonesa y de los Estados Unidos de Nor teamérica (EP, JP y USP respectivamente). Cetrimide Agar (Eur Pharm) PARA LABORATORIO AOAC / EP / ISO / HP / USP Solid culture medium for selective isolation of Pseudomonas aeruginosa according to Harmonised Pharmacopoeia Method and standard. Cetrimida agar foundation, persiapan, penggunaan itu agar setrimid atau cetrimide adalah media kultur padat selektif, yang dirancang untuk isolasi Pseudomonas aeruginosa Itu didasarkan pada menyoroti produksi karakteristik pigmen dari spesies ini dan dikembangkan dari modifikasi agar Tech, yang dibuat oleh King, Ward dan Raney.
Cetrimide Agar developed by Lowburry (8) is a modification of Tech Agar (Medium A) with addition of 01% cetrimide for selective isolation of Paeruginosa Later, due to the availability of the highly purified cetrimide, its concentration in the medium was decreased (9). CHROMID ® Culture Media Chromogenic Media for Organism Isolation and Identification CHROMID provides clear, easy to read media that can be used by trained staff to aid in infection prevention efforts to control the spread of resistance in an institution bioMérieux, Inc is a partner you can work with to enhance your antimicrobial stewardship efforts – providing faster, more accurate and. Agar Cetrimidu alebo agar cetrimidu je selektívne pevné kultivačné médium určené na izoláciu Pseudomonas aeruginosa Je založený na zvýraznení produkcie pigmentov charakteristických pre tento druh a bol vyvinutý z modifikácie Tech agaru, vytvoreného Kingom, Wardom a Raneym.
Agar cetrimida agar selectivo para Pseudomonas (base) para microbiología (According harm EP/USP/JP) Find MSDS or SDS, a COA, data sheets and more information. Baird Parker Agar was developed by Baird Parker in 1962 and is a modification of Telluriteglycine formulation of Zebovitz et al It is a moderately selective medium for the isolation and differentiation of coagulase positive Staphylococci especially Staphylococcus aureusIt is primarily used in processing of food, cosmetics and environmental samples rather than clinical samples. Description For the detection and enumeration of Pseudomonas aeruginosa according to Lowbury Mechanism of action Cetrimide medium supports the production of pyocyanin and fluorescein in the growing colonies of Pseudomonas aeruginosa and makes it easy to identify it by its color and fluorescence.
CETRIMIDE AGAR mL PL 90X15 10PL LB Rev 04 –11/19 1 INTRODUÇÃO A Pseudomonas aeruginosa (também conhecida como Pseudomonas pyocyanea) é uma bactéria gramnegativa, baciliforme (característica morfotintorial) e aeróbia Seu ambiente de origem é o solo, mas sendo capaz de viver mesmo em ambientes. Cetrimida agar foundation, förberedelse, användningar den cetrimidagar eller cetrimid är ett selektivt fast odlingsmedium, utformat för isolering av Pseudomonas aeruginosa Det bygger på att lyfta fram pigmentproduktionen som är karakteristisk för denna art och utvecklades från modifieringen av Tech agar, skapad av King, Ward och Raney. Cetrimide Agar Plate PRM024 Podloga za selektivnu izolaciju Pseudomonas aeruginosaiz kliničkih uzoraka Sastav (u 1000 mL podloge) Pankreasni hidrolizat želatina ,000 g Magnezijum hlorid 1,400 g Kalijum sulfat 10,000 g Cetrimid 0,300 g Agar 15,000 g.
Cetrimid Agar razvijen od strane Lowburry (2) je modifikacija Tech Agar (Medium A) sa dodatkom 0,1% cetrimida za selektivnu izolaciju P aeruginosa Kasnije, zbog dostupnosti visoko prečišćenog cetrimida, njegova koncentracija u podlozi je smanjena 3 Inkubacija je bila izvedena na 37° u vremenskom period od 14 sata (4). Twelve hours prior to infection, prepare two cultures of P aeruginosa in Luria broth by aseptically picking a colony from a cetrimide agar plate and inoculate 5 mL of Luria broth in a mL test tube Shake overnight at 250 rpm in a 37 °C incubator. CETRIMIDE AGAR mL PL 90X15 10PL LB Rev 04 –11/19 1 INTRODUÇÃO A Pseudomonas aeruginosa (também conhecida como Pseudomonas pyocyanea) é uma bactéria gramnegativa, baciliforme (característica morfotintorial) e aeróbia Seu ambiente de origem é o solo, mas sendo capaz de viver mesmo em ambientes.
Cetrimida agar asas, penyediaan, kegunaan The cetrimide agaratau cetrimide adalah medium budaya pepejal terpilih, yang direka untuk pengasingan Pseudomonas aeruginosa Ia adalah berdasarkan kepada penonjolan pengeluaran ciriciri pigmen spesies ini dan telah dibangunkan daripada pengubahsuaian Tech agar dicipta oleh Raja, Ward dan Raney. Laboratorios Britania SA Los Patos 2175 Ciudad Autónoma de Buenos Aires C12ABI Argentina. Cetrimida寒天ファンデーション、調製、用途 の セトリミド寒天 またはcetrimideはのために設計されている選択的な固体培地です、 緑膿菌 それはこの種に特徴的な顔料の生産を強調することに基づいていて、King、Ward、およびRaneyによって作成されたTech agarの.
BASE DE AGAR CETRIMIDA 500 G No Catálogo DIF2854 0 reseñas Escribir una reseña Los medios deshidratados se utilizan para una gran variedad de aplicaciones, tienen ventajas importantes con respecto a los medios en polvo convencionales Son de alta calidad y cumplen los estándares de control en alimentos, análisis microbiológicos de. Cetrimide selective agar is used for the selective cultivation and isolation of Pseudomonas aeruginosa isolates from clinical and nonclinical samplesThe preparation of cetrimide selective agar is elaborated in this sectionP aeruginosa is a pigmentproducing bacteriumThe organism produces certain types of pigments including pyocyanin (bluegreen pigment), pyomelanin (black pigment) and. A video less describing the use of Cetrimide agar in the isolation and identification of Pseudomonas.
Pseudomonas spp su morfología colonial es característica de identificación en algunos medios de cultivo, por ejemplo en medio agar Cetrimida, es un bacilo curvo o recto, aislado o en pareja o cadenas cortas, Gram negativa () esta bacteria tiene motilidad positiva gracias a su flagelo (solo cuenta con uno). Hey friendsI'm medical laboratory scientistThis video has information about pseudomonas aeruginosa colony morphology on MacConkey agarBlood agar(clear expl. BD Pseudosel Agar Fórmula* por litro de agua purificada Digerido pancreático de gelatina ,0 g Cloruro de magnesio 1,4 Sulfato de potasio 10,0 Glicerol 10,0 ml Cetrimida 0,3 g Agar 13,6 pH 7,2 ± 0,2 *Ajustada y/o suplementada para satisfacer los criterios de rendimiento PRECAUCIONES Solamente para uso profesional.
Cetrimide Selective Agar, USP is recommended by the US Pharmacopeia for use in the growth promotion testing of nonsterile products tests for specified microorganisms (8) Cetyltrimethylammonium bromide, a quaternary ammonium, cationic detergent, is the component of Cetrimide Agar which allows for the selective isolation of Pseudomonas. Agar cetrimida agar selectivo para Pseudomonas (base) para microbiología (According harm EP/USP/JP) Find MSDS or SDS, a COA, data sheets and more information. Ans Cetrimide agar is a type of agar which allows selective isolation of pseudomonas aeruginosa (Not clear to me) Ques What is Cetrimide cream/solution?.
El agar cetrimida o cetrimide es un medio de cultivo sólido selectivo, diseñado para el aislamiento de Pseudomonas aeruginosa Está basado en poner en evidencia la producción de pigmentos característicos de esta especie y fue elaborado a partir de la modificación del agar Tech, creado por King, Ward y Raney. Lowburry (8) is a modification of Tech Agar (Medium A) with addition of 01% cetrimide for selective isolation of Paeruginosa Later, due to the availability of the highly purified cetrimide, its concentration in the medium was decreased (9) The incubation was carried out at 37°C for a period of 14 hours (2). Cetrimida agar foundation, persiapan, penggunaan itu agar setrimidatau cetrimide adalah media kultur padat selektif, yang dirancang untuk isolasi Pseudomonas aeruginosa Itu didasarkan pada menyoroti produksi karakteristik pigmen dari spesies ini dan dikembangkan dari modifikasi agar Tech, yang dibuat oleh King, Ward dan Raney.
Cetrimida agar asas, penyediaan, kegunaan The cetrimide agar atau cetrimide adalah medium budaya pepejal terpilih, yang direka untuk pengasingan Pseudomonas aeruginosa Ia adalah berdasarkan kepada penonjolan pengeluaran ciriciri pigmen spesies ini dan telah dibangunkan daripada pengubahsuaian Tech agar dicipta oleh Raja, Ward dan Raney. Cetrimide Selective Agar, USP is recommended by the US Pharmacopeia for use in the growth promotion testing of nonsterile products tests for specified microorganisms (8) Cetyltrimethylammonium bromide, a quaternary ammonium, cationic detergent, is the component of Cetrimide Agar which allows for the selective isolation of Pseudomonas. Cetrimida agar foundation, forberedelse, anvendelser den cetrimidagar eller cetrimid er et selektivt fast dyrkningsmedium, designet til isolering af Pseudomonas aeruginosa Det er baseret på at fremhæve produktionen af pigmenter, der er karakteristiske for denne art, og blev udviklet fra modifikationen af Tech agar, skabt af King, Ward og Raney.
BD Pseudosel Agar (Cetrimide Agar) INTENDED USE BD Pseudosel Agar (Cetrimide Agar) is used for the selective isolation of Pseudomonas aeruginosa from clinical specimens PRINCIPLES AND EXPLANATION OF THE PROCEDURE Microbiological method Pseudomonas aeruginosa is an environmental organism and an important nosocomial. Selective isolation of Pseudomonas aeruginosa Ref x 90 mm. Cetrimida agar nền tảng, chuẩn bị, sử dụng các thạch cetrimide hoặc cetrimide là môi trường nuôi cấy rắn chọn lọc, được thiết kế để phân lập Pseudomonas aeruginosa.
CETRIMIDE AGAR (BASE) PHARMACOPEA MEDIO N Aislamiento selectivo para Pseudomonas aeruginosa en medicamentos (USP) y cosméticos (ISO ) COMPOSICIÓN Peptona pancreátgelatina ,0 g Cetrimida 0,3 g Cloruro magnésico 1,4 g. Cetrimide (Pseudosel) Agar is used for the selective isolation and identification of Pseudomonas aeruginosa MeetsUnited States Pharmacopeia (USP), European Pharma copoeia (EP) andJapanese Pharmacopoeia (JP)13performance specifications, where applicable. A video less describing the use of Cetrimide agar in the isolation and identification of Pseudomonas.
Description For the detection and enumeration of Pseudomonas aeruginosa according to Lowbury Mechanism of action Cetrimide medium supports the production of pyocyanin and fluorescein in the growing colonies of Pseudomonas aeruginosa and makes it easy to identify it by its color and fluorescence. Cetrimida agar foundation, förberedelse, användningar den cetrimidagar eller cetrimid är ett selektivt fast odlingsmedium, utformat för isolering av Pseudomonas aeruginosa Det bygger på att lyfta fram pigmentproduktionen som är karakteristisk för denna art och utvecklades från modifieringen av Tech agar, skapad av King, Ward och Raney. Cetrimide or Cetrimide Agar is a selective solid culture medium designed for the isolation of Pseudomonas aeruginosa It is based on showing the production of characteristic pigments of this species and was made from the modification of Tech agar, created by King, Ward and Raney.
Milliflex ® Cassette prefilled with Cetrimide Agar is used in Bioburden testing and general microbiological analysis of water especially high purity water (electronics, RO, distilled or purified) It is widely used in pharmaceutical, cosmetic and brewing industry Packaging 48 ea in 10 mL Agar in plastic Cassette. Agar, therefore, is a valuable culture medium in the identification of this organism In addition to the promotion of pyocyanin production, Pseudosel Agar also enables the detection of fluorescent products produced by P aeruginosa Cetrimide (Pseudosel) Agar is widely recommended for use in the examination of cosmetics,10 clinical specimens8. Cetrimida agar Foundation, การเตรียม, การใช้ประโยชน์ เจทริติเจล หรือเซทริไมด์เป็นสื่อวัฒนธรรมที่เป็นของแข็งซึ่งคัดเลือกมาเพื่อการแยก Pseudomonas.
Media Format Pancreatic digest of Gelatin g/L, Magnesium Chloride 14g/L, Potassium Sulfate 10g/L, Cetrimide (Tetradecyltrimethylammonium Bromide) 03g/L, Agar 136g/L. Cetrimida agar foundation, forberedelse, anvendelser den cetrimidagar eller cetrimid er et selektivt fast dyrkningsmedium, designet til isolering af Pseudomonas aeruginosa Det er baseret på at fremhæve produktionen af pigmenter, der er karakteristiske for denne art, og blev udviklet fra modifikationen af Tech agar, skabt af King, Ward og Raney. Cetrimide agar is a type of agar used for the selective isolation of the gramnegative bacterium, Pseudomonas aeruginosa As the name suggests, it contains cetrimide, which is the selective agent against alternate microbial flora.
Ans Cetrimide cream or solution is a topical form of this drug that can be applied to areas which have any sort of infections or cuts, burns and wounds. Cetrimida Agar se utiliza como un medio selectivo para el aislamiento de Pseudomonas aeruginosa de pus, esputo y desagües, etc Pseudomonas aeruginosa produce una serie de quelantes de hierro solubles en agua, incluyendo el fluorescente amarilloverde o amarillomarrón pioverdina. Cetrimide agar 4 Product Results Match Criteria Product Name, Property, Description ;.
Cetrimide Agar is used in the isolation and identification of Pseudomonas aeruginosa Conforms to Harmonized USP/EP/JP Requirements. Agar, therefore, is a valuable culture medium in the identification of this organism In addition to the promotion of pyocyanin production, Pseudosel Agar also enables the detection of fluorescent products produced by P aeruginosa Cetrimide (Pseudosel) Agar is widely recommended for use in the examination of cosmetics,10 clinical specimens8. Cetrimide Agar Página 2 de 1 OPPD63 Versión MDM CIENTÍFICA SAS Calle 7 Sur No 51 A – 90 of 102 Medellín Teléfonos (4) 285 5043 365 9180 81 Cel 311 746 8684, 315 545.
Cetrimide Agar is a selective and differential medium used for the isolation and identification of Pseudomonas aeruginosa from clinical and nonclinical specimens Cetrimide is the selective agent and inhibits most bacteria by acting as a detergent (Cetyltrimethylammonium bromide, a quaternary ammonium, cationic detergent).
Http Www Scharlabmagyarorszag Hu Katalogus 01 160 Tds En Pdf

Agar Cetrimida X 500gr Onelab Tu Tienda Online De Laboratorio

Cetrimide Agar Base European Pharmacopoeia Usp Cat Nº 1102 Pseudomonas Aeruginosa

Cetrimide Agar Pseudomonas Aeruginosa Isolation Sigma Aldrich

Cetrimide Selective Agar Preparation Microdok Microbiology

l Prepared Plated Media Pseudosel Agar Cetrimide Agar Pseudosel Fisher Scientific

Milliflex Cassette Prefilled With Cetrimide Agar Mxsmcet48

Cetrimide Selective Agar For Pseudomonas Aeruginosa

Cetrimide Agar Flashcards Pseudomonas Aeruginosa Flashcards Biofilm

Pseudomonas Selective Agar Cetrimide Nalidixic Acid Pseudomonas Cn 90mm Plate Southern Group Laboratory

Show Pseudomonas Aregenosa Colony On Cetrimide Agar Download Scientific Diagram

Cetrimide Agar Three Strains Of Pseudomonas Aeruginosa On Cetrimide Agar Pyocyanin And Pyoverdine Pigments Color
Labchem Wako Fujifilm Com Jp Category Docs Doc08 Pdf

Cetrimide Agar Eur Pharm Scharlab Com Scharlab S L The Lab Sourcing Group

Ridacom Comprehensive Bioscience Supplier Cetrimide Agar Base Ep

Enumerating Antibiotic Susceptibility Patterns Of Pseudomonas Aeruginosa Isolated From Different Sources In Dhaka City

Cetrimide Agar Usp Ep Products Fisher Scientific

Pseudomonas Aeruginosa Was Growth In Cetrimide Agar Stock Photo Download Image Now Istock
Q Tbn And9gctqz9uojnluz7jczf7raoz1b9biurnwexstclmurki Usqp Cau

Agar Cetrimide Quios
Hyserve

Cetrimide Agar Plate अगर प ल ट In Bhayandar East Mumbai Virtue Bios Technologies Id

Cetrimide Selective Agar For Pseudomonas Aeruginosa

Cetrimide Agar Mycrobe

Agarcetrimide Instagram Posts Gramho Com

1029 A Agar Cetrimida Base Laboteca

Cetrimide Agar

It S Not Rocket Science Pseudomonas Aeruginosa Culture On Nutrient Agar

Borosilicate Glass Cetrimide Agar Plate Rs 45 Piece Cemil Biosciences Id

Why When I Incubate Pseudomonas In Medium With Cetrimide For 10 Days Do I Get The Following Patterns

Cetrimide Agar Growth Of Pseudomonas Aeruginosa On Cetrimide Agar Plate Petri Dish With Cetrimide Agar

Cetrimide Agar Pseudomonas Aeruginosa Sigma Aldrich

Cetrimide Agar Base Cetrimide Agar Plate Cetrimide Agar Is Used For Selective Isolation Of Pseudomonas Aeruginosa From Clinic Agar Pseudomonas Aeruginosa Base
Http Www Scharlabmagyarorszag Hu Katalogus 01 160 Tds En Pdf

Figure 1 From Isolation And Screening Of Biosurfactants Produced By Pseudomonas Aeruginosa From Oil Spilled Soils Semantic Scholar

Dcm For The Harmonised Pharmacopoeia Lab M

Cetrimide Agar 500 G Himedia Mh024 Grupo Didacta

Pseudomonas Selective Agar Cetrimide Fucidin Cephalosporin Cfc 55mm Plate Southern Group Laboratory

Pseudomonas Aeruginosa Was Growth In Cetrimide Agar Stock Photo Download Image Now Istock
Pharmaceutical Microbiology Cetrimide Agar Ca

Cetrimide Agar Green Color Of Pseudomonas Aeruginosa Pigment On Cetrimide Agar Pyocyanin And Pyoverdine Pigments Colour

Cetrimide Selective Agar Macconkey Agar Vogel Johnson Agar Plate
Http Com Resource Aspx Idx 9002

Cetrimide Agar Plate 14cm
Www Com Europe Regulatory Assets Ifu Difco l 2854 Pdf

Remel Cetrimide Selective Agar Dehydrated

Cetrimide Agar Base C03 107 Alpha Biosciences

Cetrimide Agar

Pseudomonas Aeruginosa Main Responsible For Cosmetic Recalls

Morphology Culture Characteristics Of Pseudomonas Aeruginosa
Http Mdmcientifica Com Wp Content Uploads 16 12 Cetrimide Medio Agar Mdm Cient C3 Adfica Inserto O P Pd 63 Pdf

Jual Cetrimide Agar Merck 500 Gr Kab Malang Kimia As Tokopedia

Biotecnologia Para Descontaminacion Una Bacteria Que Transforma Suelos

Pseudomonas Aeruginosa P Putida P Fluorescens Morfologia Medios De Cultivo Enfermedades Y Mas Microbitos Blo Medio De Cultivo Morfologia Enfermedades

Cetrimide Selective Agar

Cetrimide Agar Moi Trường Cetrimide Thạch Cetrimide Ct Bimetech

New Thermo Scientific Medium Enhances The Identification Of

Agar Cetrimide X 500gr Merck Medio De Cultivo Mercado Libre
Q Tbn And9gctefycdhnynioi7kgipkpln0ovqbzk1mxi04brg4hvwk5xyhs7g Usqp Cau

Cetrimide Agar Composition Principle Uses Preparation And Colony Morphology

Fluorescence Of Pseudomonas Aeruginosa Under Uv Light On Cetrimide Agar Fluorescent Pigment Of P Aeruginosa Pyoverdine Pyoverdin
Q Tbn And9gctoyx2xuzg Pxs3en6wsizvlgztu4e3hczcxkv1jfuspmbefshf Usqp Cau

Cetrimide Agar Sem Az

Cetrimide Agar Base

Cetrimide Nalidixic Pseudomonas Cn Agar

Cetrimide Agar Test Principle Procedures Results Uses

Pyocyanin Production Of P Aeruginosa Cu1 On Cetrimide Agar Plate Download Scientific Diagram

Growth Of Separated P Aeruginosa On A Mha Plate A And On A Cetrimide Download Scientific Diagram

𝘗𝘴𝘦𝘶𝘥𝘰𝘮𝘰𝘯𝘢𝘴 𝘢𝘦𝘳𝘶𝘨𝘪𝘯𝘰𝘴𝘢 Atcc 9027 En Agar Cetrimida Catalogo 1029 Medio De Cultivo Microbiologia Microorganismos

Cetrimide Agar Eur Pharm Scharlab Com Scharlab S L The Lab Sourcing Group
Www Emdmillipore Com Web Ca Site En Ca Cad Showdocument File Productsku Mm Nf Hawg047s6 Documentid 1710 067 Pronet Documentuid Documenttype Ti Language En Country Nf Origin Pdp

Pseudomonas Selective Agar Cetrimide Nalidixic Acid Pseudomonas Cn Contact Plate Southern Group Laboratory

Growth In Cetrimide Agar Download Scientific Diagram

Medio De Cultivo Deshidratado Cetrimide Agar Base X 500g Quimi Lab

Thermo Scientific Pseudomonas C N Selective Agar Cetrimide Agar 17ml 17g 5 Products Fisher Scientific

Cetrimide Agar Culture Media Microbe Notes

Rich Davis Phd D Abmm Mls This Is Just Routine Mh Agar The Agars That Help To Induce Pyocyanin Production Are Cetrimide And Tech Pseudomonas Agar F Agar See Pic

Pseudomonas Aeruginosa Colonies On Cetrimide Agar

Mannitol Salt Agar Png Images Pngwing

Biomerieux Culture Media Product Cetrimide Agar

90 Mm Cetrimide Agar Plate Application For Lab Price Range 30 00 100 00 Inr Piece Id C

A Colonies Of Ps Aeruginosa On Cetrimide Agar Download Scientific Diagram

Single Colony Of Bacteria On Agar Cetrimide Media Download Scientific Diagram

Biol 230 Lab Manual Pigmentation Of Pseudomonas On Pseudosel Gar
Http Www Analisisavanzados Com Modules Mod Tecdata Normas Cosmetica Iso Ficha Pseudomonas Aeruginosa Pdf

Cetrimide Agar For Microbiology Pseudomonas Selective Agar Sigma Aldrich
Www Merckmillipore Com Intershop Web Wfs Merck Fr Site Fr Fr Eur Showdocument File Productsku Mda Chem Documentid 1603 011 Pronet Documenttype Ds Language En Country Nf Origin Pdp

Cetrimide Cromogenic Agar Base
Hyserve

Cetrimide Test Principle Procedure Uses And Interpretation

Tm Media Cetrimide Agar Base 100g Amazon In Industrial Scientific

Cetrimide Agar Youtube

Pdf Molecular Characterization Of Pathogenic And Non Pathogenic Pseudomonas Aeruginosa With Special Reference To Phenazine Gene Semantic Scholar

Pseudomonas Aeruginosa Em Cetrimida Agar Em Biologia Microbiologia Agar

Agar Cetrimida Fundamento Preparacion Usos
1

Cetrimide Agar Flashcards Flashcards Agar How To Memorize Things

Cetrimid Agar Wikipedia



